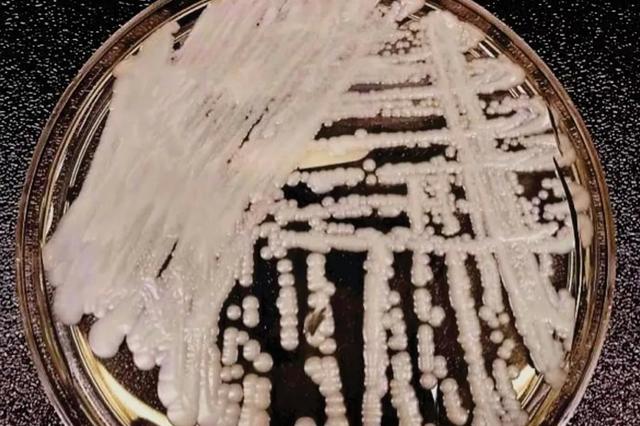
超级真菌大爆发?专家:健康人群不会感染无需恐慌

超级真菌大爆发?专家:健康人群不会感染无需恐慌
小编提示您:本篇文章标题是《超级真菌大爆发?专家:健康人群不会感染无需恐慌》,来源是:新京报。//本文由热心网友[瑞瑞妈妈] 投稿。 超级真菌大爆发?专家:健康人群不会感染无需恐慌.www.jiangsulong.com//本文由热心网友[环境卫生管理] 投稿。
超级真菌大爆发?专家:健康人群不会感染无需恐慌//www.jiangsulong.com//本文由热心网友[显老的其实不是皱纹] 投稿。来源是:新京报
致死率超60%、近50%感染者90天内死亡……近日,一则“超级真菌被美列为紧急威胁、中国已有18例确认感染”的消息刷屏,引发公众恐慌。
专家表示,公众不必过分担心,“超级真菌”感染主要发生在医院内部,特别是ICU内,免疫缺陷人群存在感染可能,对多数感染者现有抗菌药物治疗有效,健康人群不会感染耳念珠菌。
不过,他同时提醒,目前全球感染者数量确实越来越多,可称为爆发性流行。这一现象的出现或许与人类生活方式、医疗方式有关。
“超级真菌”来源目前仍不明确
超级真菌大爆发?专家:健康人群不会感染无需恐慌.www.jiangsulong.com//本文由热心网友[环境卫生管理] 投稿。
近日,《纽约时报》报道,一种名为耳念珠菌的“超级真菌”在美国多地爆发,目前美国已有587例确诊病例。该真菌导致病人“神秘感染”,并被美国疾病防控中心(CDC)列为“紧急威胁”,近50%感染者在90天内身亡。昨日,中国媒体发布消息称,目前中国确诊18例超级真菌感染。
超级真菌大爆发?专家:健康人群不会感染无需恐慌//www.jiangsulong.com//本文由热心网友[显老的其实不是皱纹] 投稿。来源是:新京报

培养皿中的耳念珠菌菌株。图源:美国CDC官网
“超级真菌”相关话题一度登上微博热搜榜。不少网友在留言中表示担忧:“好可怕,我们应该注意什么?”“害怕!普通民众该怎么防护?”
推荐阅读
- 娄艺潇|娄艺潇把自己作死了,直播带货大变脸,马脸嘟嘟唇超级违和!
- 时尚|新年战袍赶紧安排起来!内搭外搭超级百搭,关键显气质
- 超级英雄|漫威在国内遇冷,其他超级英雄电影迎来春天,DC首部电影或将引进!
- 太宗李芳远|韩剧《太宗李芳远》爆发「虐马致死」拍摄争议 3.6万网友怒上青瓦台连署停播
- 开端|《开端》:这才叫爆发力,黄觉和刘丹给流量们好好上了一课!
- 超级英雄|12部DC超级英雄电影,看看DC如何把漫威踩在脚底下的。
- 贝克汉姆|贝克汉姆大儿子婚礼定档,在女方家豪宅举办,亲家超级有钱
- 迪迪|正直博户外主播与明星安保人员爆发冲突,双方起口角险些爆发肢体冲突!
- 超级英雄|18线的DC英雄,成就HBO开年力作
- 景甜|《家族荣耀》剧情大反转,原来甄芯才是剧中的超级玩家

















